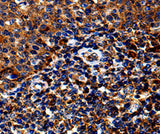
IL13RA1 Polyclonal Antibody Store at -20°C

IL13RA1 Polyclonal Antibody Store at -20°C
SKU: E-AB-10102-200
IL13RA1 Polyclonal Antibody Store at -20°C
| SKU # | E-AB-10102 |
| Reactivity | Human, Mouse |
| Host | Rabbit |
| Applications | IHC |
Product Details
| Isotype | IgG |
| Host | Rabbit |
| Reactivity | Human, Mouse |
| Applications | IHC |
| Clonality | Polyclonal |
| Immunogen | Recombinant protein of human IL13RA1 |
| Abbre | IL13RA1 |
| Synonyms | CD213A, IL13RA1, CD213A1, CT19, IL-13Ra, NR4, IL13R, IL13RA, IL-13Ra1, alpha 1), bB128O4.2.1 (interleukin 13 receptor, Cancer/testis antigen 19, CD213A1 Antigen, CT 19, I13R1, IL 13 receptor subunit alpha 1, IL 13R alpha 1, IL 13R subunit alpha 1, IL 13Ra, IL 13RA1, IL13 receptor alpha 1 chain, IL-13 receptor subunit alpha-1, IL-13R subunit alpha-1, IL-13R-alpha-1, Interleukin 13 receptor alpha 1, Interleukin 13 receptor alpha 1 chain, interleukin 13 receptor subunit alpha 1, Interleukin-13 receptor subunit alpha-1, NR 4, NR4 |
| Swissprot | |
| Cellular Localization | Membrane. |
| Concentration | 0.9 mg/mL |
| Buffer | Phosphate buffered solution, pH 7.4, containing 0.05% stabilizer and 50% glycerol. |
| Purification Method | Affinity purification |
| Research Areas | Cancer, Immunology, Signal Transduction |
| Conjugation | Unconjugated |
| Storage | Store at -20°C Valid for 12 months. Avoid freeze / thaw cycles. |
| Shipping | The product is shipped with ice pack,upon receipt,store it immediately at the temperature recommended. |
Related Reagents
| Applications | Recommended Dilution |
| IHC | 1:50-1:200 |
Background
The protein encoded by this gene is a subunit of the interleukin 13 receptor. This subunit forms a receptor complex with IL4 receptor alpha, a subunit shared by IL13 and IL4 receptors. This subunit serves as a primary IL13-binding subunit of the IL13 receptor, and may also be a component of IL4 receptors. This protein has been shown to bind tyrosine kinase TYK2, and thus may mediate the signaling processes that lead to the activation of JAK1, STAT3 and STAT6 induced by IL13 and IL4.